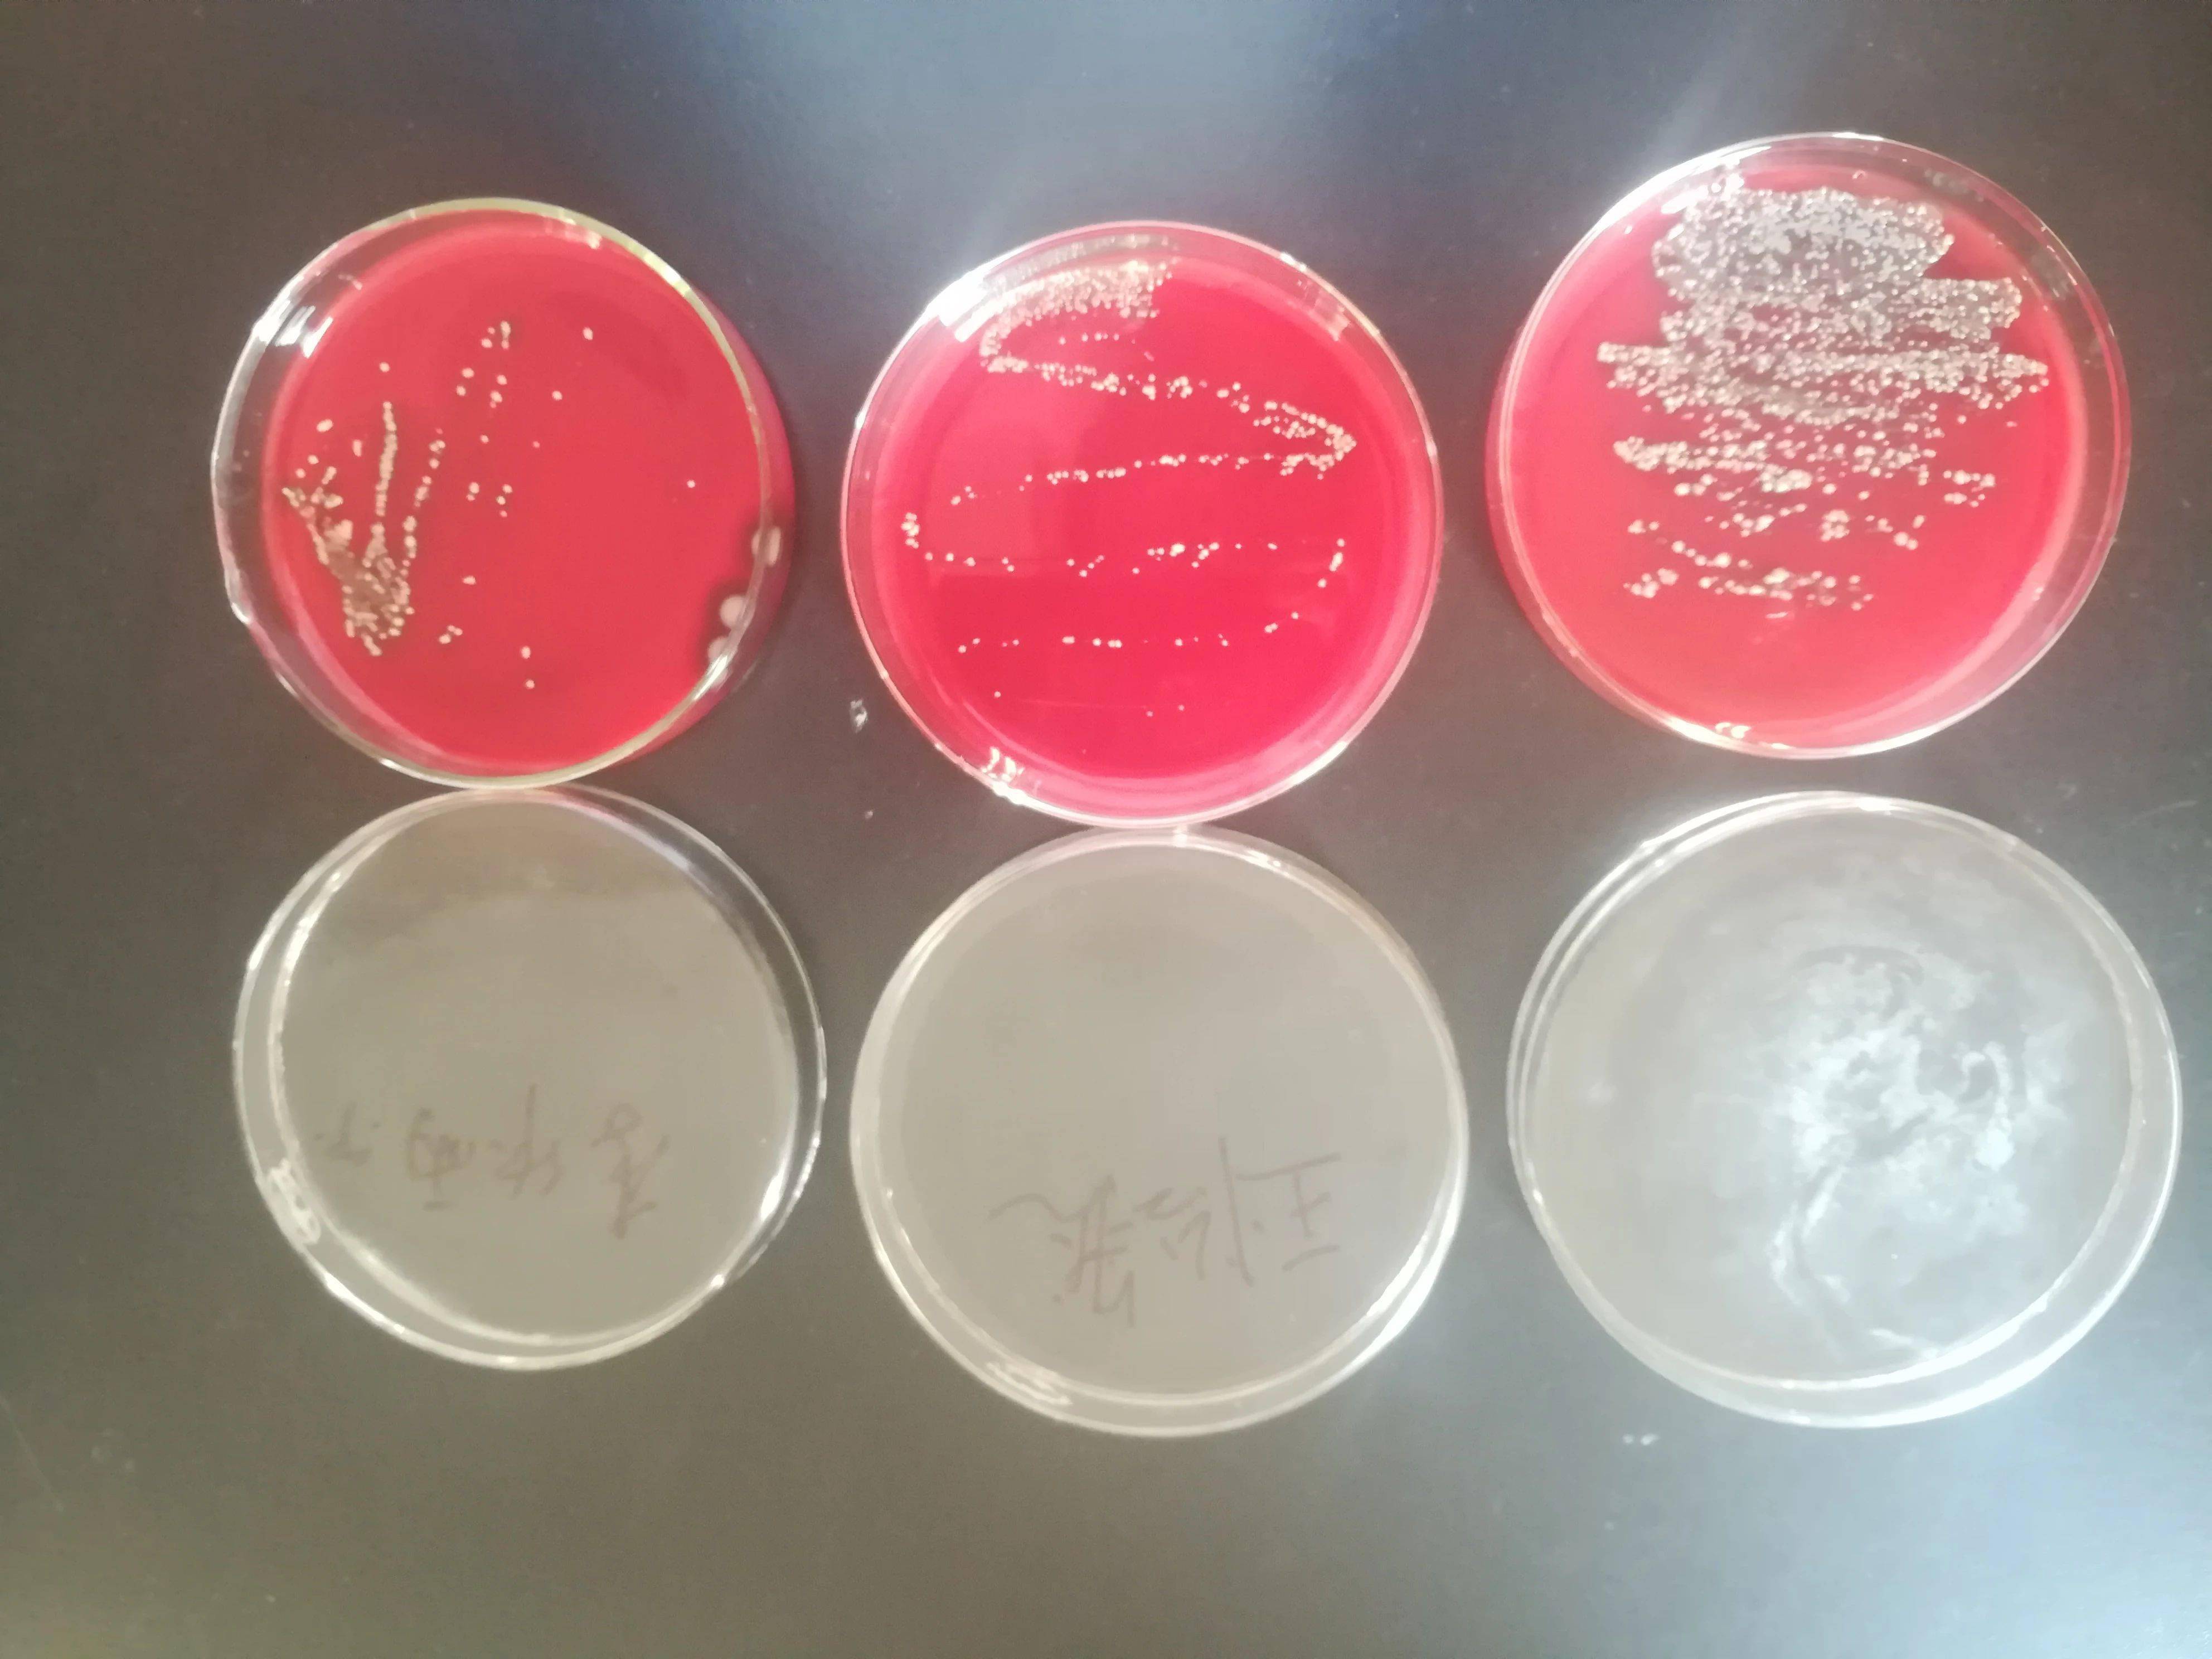
如何给细菌染色高中生如何跟博导做科研记2021温州市科技青苗计划

细菌染色剂

比克曼生物革兰氏染色液复染液碘液脱色液结晶紫显微镜细菌染色剂
图片尺寸800x800
定制快速革兰氏染色液脱色液100250贝索baso显微镜用生物细菌染色剂
图片尺寸750x840
染色纸_03.jpg
图片尺寸790x1232
细菌l型菌落染色液 50ml 科研实验试剂 现货促销
图片尺寸1080x1080
革兰氏染色液试剂盒 20ml*4支 4*2支10ml 杭州微生物
图片尺寸800x800
革兰氏染色液细菌革兰氏染色环凯029010
图片尺寸750x1041
戈登链球菌引起感染性心内膜炎的隐型杀手
图片尺寸660x676
染色兰氏试剂hb8278青岛海博细菌5ml8支其它
图片尺寸800x800
生物染色细菌细胞酵母菌化验室溶液美蓝试剂比克其它
图片尺寸800x800
生物染色细菌细胞酵母菌化验室溶液美蓝试剂比克其它
图片尺寸800x800
染色迪夫快速显微镜生物细胞血液分泌物排卵涂片试剂
图片尺寸750x750
baso瑞氏姬姆萨染色液剂细菌细胞涂片实验室显微镜用吉姆萨
图片尺寸800x800
如何给细菌染色高中生如何跟博导做科研记2021温州市科技青苗计划
图片尺寸3968x2976
比克曼生物抗酸染色液热染法20ml*4瓶用于分歧杆菌诺卡菌细菌
图片尺寸800x800
抗酸染色比克细菌结核菌荧光杆菌菌体试剂20mlusb多功能数码宝
图片尺寸800x800
瑞氏姬姆萨染色液染色剂显微镜用生物病理染液细胞染色液细菌染色
图片尺寸800x800
远慕试剂细菌细胞壁的染色实验
图片尺寸4032x3024
戈登链球菌引起感染性心内膜炎的隐型杀手
图片尺寸660x662
珠海贝索革兰氏染色液快速法4100ml用于细菌的涂片染色
图片尺寸800x800
真菌荧光染色液
图片尺寸989x716